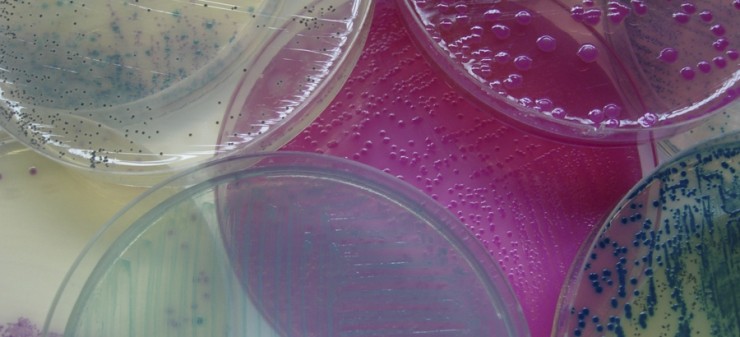

‘Consolidación de la recuperación económica’. Bajo este título se celebra esta mañana una charla-coloquio organizada por Diario de Burgos y patrocinada por Banco Santander en la que el principal protagonista será el ministro de Economía y Competitividad, Luis de Guindos, que llega a la ciudad después de participar en las intensas jornadas de negociación de la deuda griega desarrolladas durante los últimos días en Bruselas.
El representante del Gobierno abordará esta mañana en la tercera planta del Fórum Evolución, y ante una nutrida representación del empresariado y la política de Burgos y el conjunto de Castilla y León, la actualidad económica de nuestro país en la fase final de la actual legislatura y las perspectivas de futuro, así como el complejo momento por el que atraviesa el conjunto de la Unión Europea.
En la charla-coloquio también estará presente el presidente de la Junta de Castilla y León y candidato para la reelección, Juan Vicente Herrera, que será el encargado de presentar al ponente antes de su intervención y que, a buen seguro, traza también su visión del panorama económico regional.
Asimismo, en la mesa principal estarán presentes el director general del Banco Santander, Enrique García Candelas, y el presidente del Grupo Promecal, Antonio Méndez Pozo. Tras la finalización de la ponencia del ministro, se desarrollará un breve coloquio con las preguntas del público asistente moderado por el director de Diario de Burgos, Raúl Briongos.
Fuente: Diario de Burgos / Foto: Vozpopuli